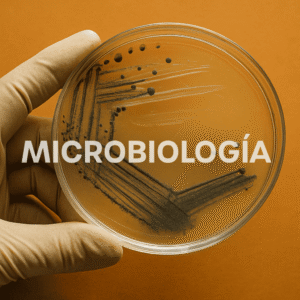

Servicios
Al elegir a Wissenschaft
como tu proveedor de equipos, disfrutarás de una serie de beneficios que incluyen:
Soporte técnico 24/7

Estamos aquí para atender tus consultas en cualquier momento. Tu satisfacción y confianza son nuestra prioridad, nuestro equipo está disponible para brindarle asistencia rápida y eficiente.
Personal capacitado

Capacitamos a nuestro personal de manera continua con el objetivo de resolver todas tus dudas y proporcionarte asesoramiento especializado. Nuestro compromiso es asegurarnos de que recibas el soporte necesario para satisfacer todas tus necesidades.
Instalación de equipos

La instalación de equipos es un proceso crucial para asegurar un funcionamiento óptimo en tu laboratorio. Nos aseguramos de que todo esté configurado y funcionando correctamente, para que puedas empezar a trabajar sin preocupaciones. Tu satisfacción y el rendimiento de tus equipos son nuestra principal prioridad.
Entregas confiables

Nuestra prioridad es garantizar que recibas tus equipos de manera segura. Contamos con un sistema de entregas confiables que se adapta a tus necesidades. Puedes confiar en que tu pedido llegará puntualmente y en perfectas condiciones.
Innovación continua

Siempre estamos a la vanguardia en la industria de la tecnología de diagnóstico, nos esforzamos por brindarte acceso a los mejores equipos y marcas disponibles en el mercado, lo que te permitirá mantener la excelencia en tus operaciones, ofreciendo resultados precisos y confiables.

Somos una empresa mexicana dedicada a la distribución de equipo de diagnóstico e investigación. Nuestro objetivo es el compromiso de llevar a cada cliente a través del esfuerzo de nuestros profesionales y la sinergia creativa que resulta de la confianza de cada prospecto, innovación, consultoría científica y de procesos de acreditación, así como plataformas, sistemas y analizadores de última generación, que permita elevar el nivel de competitividad.